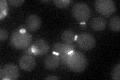
YKL101W
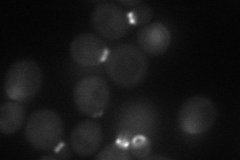
YKL101W
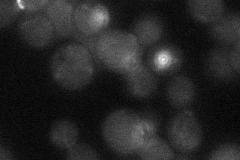
YKL101W
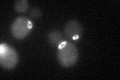
YKL101W

View description
Nim1p-related protein kinase that regulates the morphogenesis and septin checkpoints; associates with the assembled septin filament; required along with Hsl7p for bud neck recruitment, phosphorylation, and degradation of Swe1p
Localization:
Intensity:
Fold change:
Significance:
-
C’ GFP library in SD
bud neckN/A -
N' NOP1pr-GFP in SD
bud neck47.8091 -
N' TEF2pr-mCherry in SD

bud neck13.4938 -
N' NATIVEpr-GFP in SD
bud neck20.6358 -
N' TEF2pr-VC and Cyto-VN in SD

bud neck26.133 -
C’ GFP library in SD+DTT
bud neck21.151.04No -
C’ GFP library in SD+H2O2

bud neck22.661.12No -
C’ GFP library in Starvation Media

cytosol15.970.79No -
C’ GFP library on the background of Pup2-DaMP

bud neck -
C’ GFP library on the background of CCT mutant

bud neck22.08621.09394No
